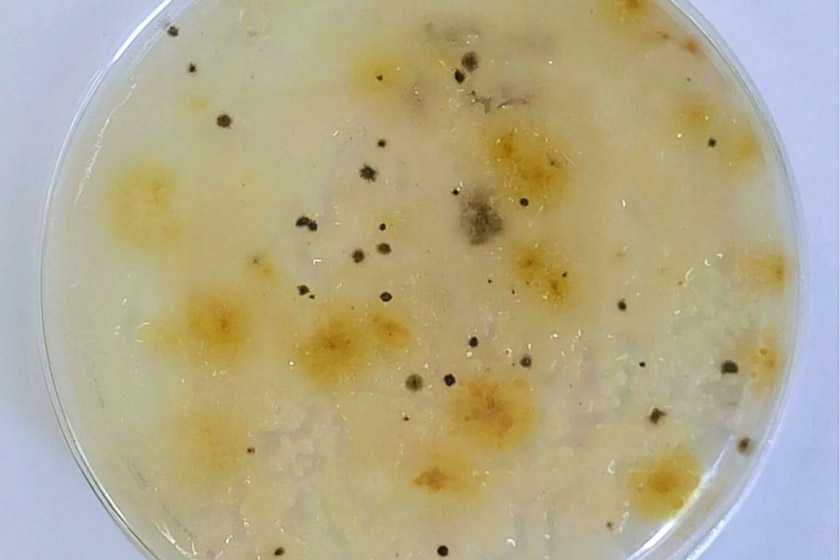

BIOTECNOLOGÍA
INVESTIGACIÓN
Buscan frenar una gramínea que amenaza la productividad y la biodiversidad en los campos fueguinos. Especialistas del INTA y del CADIC-Conicet avanzan en una línea experimental que apunta a preservar especies forrajeras reduciendo el uso de herbicidas de síntesis.


Un equipo de investigadores estudia el uso de microorganismos nativos del suelo para el control biológico de Hieracium pilosella, una gramínea que disminuye la cantidad y calidad de los pastizales en Tierra del Fuego.
El trabajo -que se encuentra en etapa inicial- apunta a frenar el avance de esa especie (conocida comúnmente como pilosela) y recuperar los pastizales naturales, reducir el uso de herbicidas y aportar a la sustentabilidad de la ganadería en la isla ubicada en el extremo sur de la Patagonia Argentina.
El estudio, que llevan adelante especialistas del INTA y del CADIC–Conicet, forma parte de un proyecto presentado por la Secretaría de Desarrollo Productivo y PyME del Gobierno de Tierra del Fuego y financiado por el Consejo Federal de Inversiones (CFI).
En los pastizales de la isla, la pilosela compite con las gramíneas nativas y forrajeras, lo que disminuye la cantidad y calidad de alimento disponible tanto para el ganado doméstico como para la fauna nativa.
Macarena Cardozo, becaria de la Agencia de Extensión Rural Río Grande del INTA, acotó que «además, forma rodales monoespecíficos (de una sola especie) que reducen la diversidad vegetal y dificultan la recuperación natural del pastizal» .
«Para una provincia cuya producción ganadera depende en gran medida de la salud de los pastizales naturales, Hieracium pilosella representa una amenaza significativa» remarcó la investigadora.
La pilosela es una hierba perenne invasora de origen euroasiático que se caracteriza por formar rosetas con hojas pubescentes y propagarse por estolones formando verdaderas alfombras vegetales que colonizan rápidamente el suelo.
También se extiende mediante la dispersión de semillas que pueden ser transportadas por el viento a largas distancias. Esta capacidad colonizadora la convierte en una especie invasora de alto impacto cuando se establece en nuevos ambientes.
Cardozo indicó que «actualmente se observa esta hierba en parches que pueden alcanzar entre un 10% y un 70% de cobertura en algunos potreros» y que «se encuentra presente en toda la isla, con mayor predominancia en la ecorregión de estepa magallánica y en menor medida en ecotono» .
El ecotono es una zona de transición entre dos ecosistemas distintos. En este caso, se refiere al espacio que comparten el bosque de lenga y otras especies arbóreas, con las que son propias de la estepa. (Nota de la Redacción de Campo Andino).

PRIMEROS PASOS. Los investigadores recolectaron muestras de suelo; aislaron bacterias, hongos y cianobacterias; y están evaluando su capacidad para inhibir la germinación o el crecimiento de la pilosela. FOTOS / GENTILEZA INTA Informa.
Un reporte de INTA Informa -que refleja los tramos salientes del diálogo de sus cronistas con las especialistas- señala que las estrategias para enfrentar la expansión de la pilosela en Tierra del Fuego son diversas, aunque ninguna resulta suficiente por sí sola.
Apunta que, «en la práctica, algunos establecimientos agropecuarios han optado por aplicar control químico mediante pulverizaciones terrestres en parches de gran cobertura, ya que no existe un trabajo sistemático de detección temprana ni de control sobre focos incipientes» .
Aclara, sí, que «el uso selectivo de herbicidas demostró reducir la cobertura de la especie invasora en los potreros tratados y favorecer la recuperación parcial del pastizal natural».
Sin embargo -advierte- «se trata de una herramienta con múltiples limitaciones: requiere maquinaria específica, depende de un período muy breve de condiciones climáticas adecuadas para la aplicación y demanda mano de obra especializada, escasa en la región».
Cardozo indicó que «a estas dificultades se suma que la tasa de crecimiento anual de la pilosela ronda entre el 15% y el 20%, lo que implica que la superficie tratada cada año es reducida en comparación con la superficie ya invadida o en proceso de expansión» .
Esto, con un agravante: «las tareas -lamenta la investigadora- se realizan de manera aislada por parte de productores individuales» debido a que «no existe un plan integral de manejo a nivel provincial o regional» .
En paralelo, se implementaron otras medidas como la mejora del tapiz forrajero mediante resiembras y fertilización, con el objetivo de fortalecer la competencia de las gramíneas deseadas y el ajuste del manejo del pastoreo para evitar la degradación, que favorece la invasión.
Es en este contexto que se están realizando estudios sobre el uso de microorganismos nativos con potencial antagonista, con el objetivo de generar conocimiento que, a futuro, pueda sumarse a las herramientas disponibles.
Noelia Paredes -investigadora de la Agencia de Extensión Rural Ushuaia del INTA– explicó que «se trata de un estudio exploratorio orientado a generar conocimiento científico y evaluar si estos microorganismos o sus extractos pueden ser útiles en un futuro como parte de un manejo integrado» .
Detalló que recolectaron muestras de suelo; aislaron bacterias, hongos y cianobacterias; y están evaluando su capacidad para inhibir la germinación o el crecimiento de la pilosela (la gramínea que tratan de combatir).
El reporte de INTA Informa remarca que «no se plantea como una solución única ni inmediata, sino como una línea de investigación que busca aportar opciones complementarias dentro de un manejo integrado» .
Apunta que, en este enfoque integral, deberían confluir «distintas prácticas para enfrentar de manera más sostenible la expansión de la pilosela en los pastizales fueguinos».
Aclara que el proyecto cuenta con el apoyo de Estancia Cullen, que facilita el acceso a los sitios de muestreo y la logística necesaria para el trabajo de campo.
«El establecimiento, pionero en promover el desarrollo de alternativas biológicas de control, tuvo un rol central en la gestación de la iniciativa» finaliza el informe.
AER INTA RÍO GRANDE AER INTA USHUAIA CADIC-CONICET CONTROL BIOLÓGICO DE MALEZAS ESTANCIA CULLEN TIERRA DEL FUEGO ESTEPA MAGALLÁNICA HIERACIUM PILOSELLA MACARENA CARDOZO INVESTIGADORA MANEJO INTEGRADO DE MALEZAS EN PASTIZALES NOELIA PAREDES INVESTIGADORA PATAGONIA SUR ARGENTINA PILOSELA RECUPERACIÓN DE PASTIZALES EN TIERRA DEL FUEGO SECRETARÍA DESARROLLO PRODUCTIVO TIERRA DEL FUEGO TIERRA DEL FUEGO ARGENTINA




